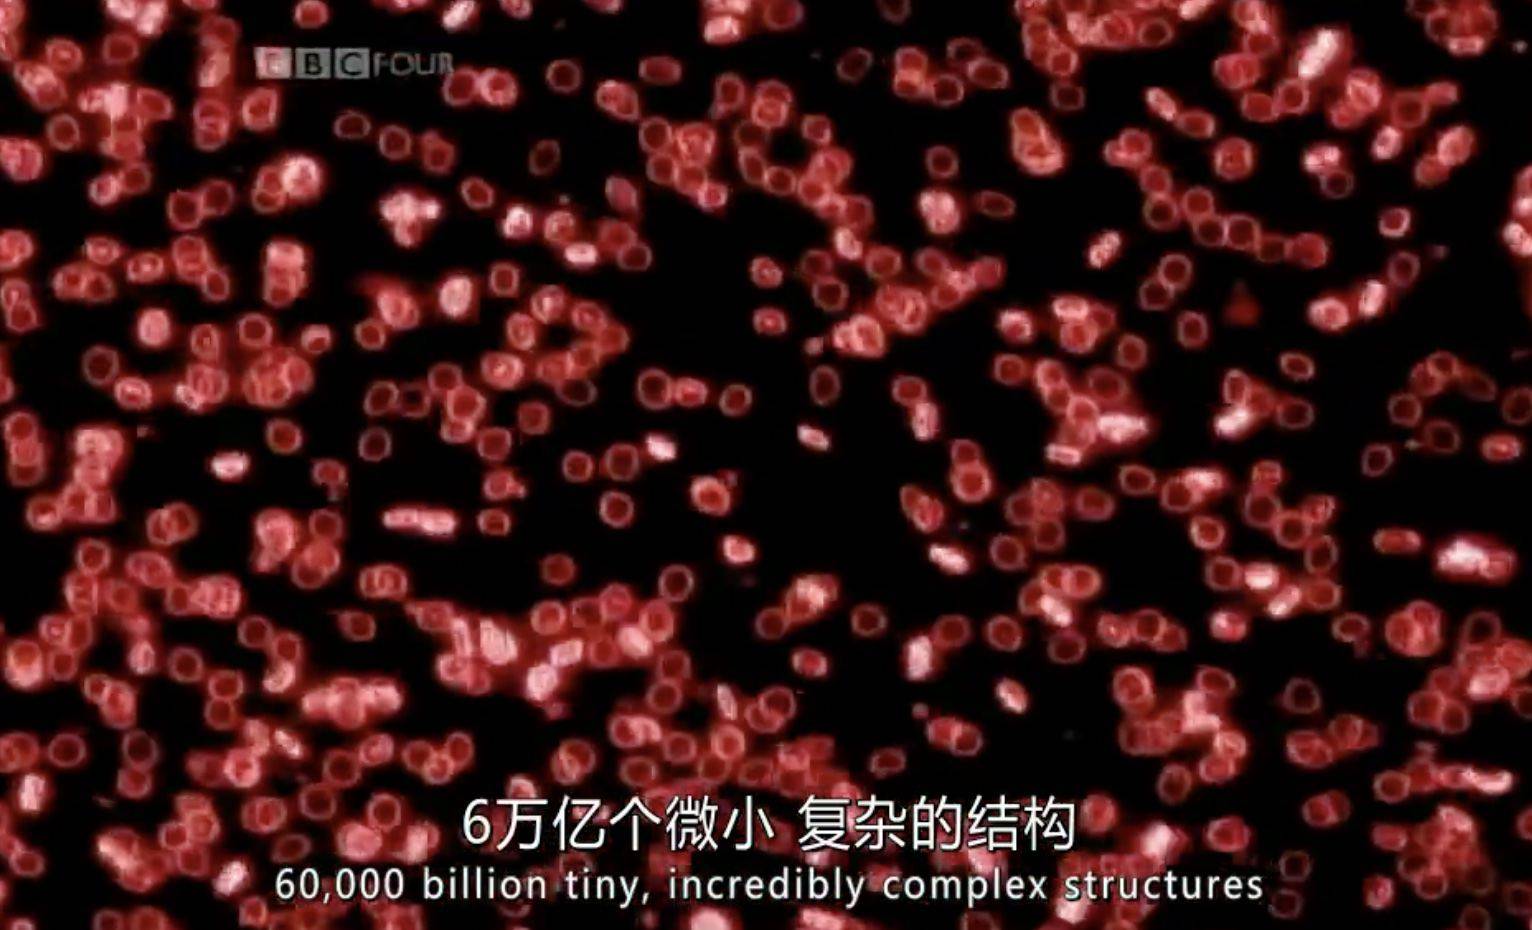
bbc纪录片《细胞 the cell 2009》全3集 中文字幕 720p高清_生命_亚当

cell细胞电影
![蓝光电影|蓝光原盘 [入侵脑细胞2].the.cell.2.2009.usa.bluray.](https://i.ecywang.com/upload/1/img2.baidu.com/it/u=2724880478,3144571196&fm=253&fmt=auto&app=138&f=JPEG?w=500&h=281)
蓝光电影|蓝光原盘 [入侵脑细胞2].the.cell.2.2009.usa.bluray.
图片尺寸1600x900
病毒入侵的故事—bbc细胞的暗战the hidden life of the cell
图片尺寸600x336
bbc纪录片《细胞 the cell 2009》全3集 中文字幕 720p高清_生命_亚当
图片尺寸1532x930
0416615入侵脑细胞the cell (2000).6526615人工智能a.i.
图片尺寸1080x1440
入侵脑细胞2 - the cell 2 - 正版蓝光原盘iso - 蓝光电影下载
图片尺寸540x800
细胞分裂 6:黑名单 - tom clancys splinter cell: blacklist
图片尺寸1920x1080
《细胞分裂6:黑名单(splinter cell: blacklist)》pc,ps3中文版上市
图片尺寸500x281
细胞分裂 6:黑名单 - tom clancys splinter cell: blacklist
图片尺寸1920x1080
《 细胞分裂 6:黑名单(splinter cell Ⅵ:blacklist)》版区版规
图片尺寸1920x1080
t淋巴细胞详解_功能_免疫_cell
图片尺寸855x605
细胞分裂 3:混沌理论 hd - tom clancys splinter cell: chaos
图片尺寸720x720
登上《细胞》封面!我国成功破解这一世界性难题|基因_新浪财经_新浪网
图片尺寸900x1135
入侵脑细胞 - the cell - 正版蓝光原盘iso - 蓝光电影下载 - powered
图片尺寸540x800
英国版cell细胞杂志2013年合集全25本
图片尺寸900x900
10月有哪些研究登上了cellpress期刊封面
图片尺寸591x768
biol:细胞骨架或可诱发细胞增殖 或为揭示肿瘤形成提供线索 - cell
图片尺寸425x334
cellpress期刊6月封面一览你的浪花给哪一张
图片尺寸591x768
细胞分裂 6:黑名单 - tom clancys splinter cell: blacklist
图片尺寸1920x1080
细胞分裂 6:黑名单 - tom clancys splinter cell: blacklist
图片尺寸1920x1079![蓝光电影|蓝光原盘 [入侵脑细胞2].the.cell.2.2009.usa.bluray.](https://i.ecywang.com/upload/1/img0.baidu.com/it/u=2450083874,2341009068&fm=253&fmt=auto&app=138&f=JPEG?w=500&h=281)
蓝光电影|蓝光原盘 [入侵脑细胞2].the.cell.2.2009.usa.bluray.
图片尺寸1600x900
![蓝光电影|蓝光原盘 [入侵脑细胞2].the.cell.2.2009.usa.bluray.](https://i.ecywang.com/upload/1/img2.baidu.com/it/u=2724880478,3144571196&fm=253&fmt=auto&app=138&f=JPEG?w=500&h=281)
















![蓝光电影|蓝光原盘 [入侵脑细胞2].the.cell.2.2009.usa.bluray.](https://i.ecywang.com/upload/1/img0.baidu.com/it/u=2450083874,2341009068&fm=253&fmt=auto&app=138&f=JPEG?w=500&h=281)
![蓝光电影|蓝光原盘 [入侵脑细胞2].the.cell.2.2009.usa.bluray.](https://www.hdshare.cn/contents/3795/2.jpg?lightbox[modal]=true)

![蓝光电影|蓝光原盘 [入侵脑细胞2].the.cell.2.2009.usa.bluray.](https://www.hdshare.cn/contents/3795/1.jpg?lightbox[modal]=true)